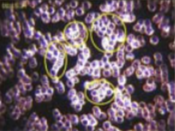

Our Discovery of Uniwave Pendant
Our Discovery of Uniwave Pendant
Before using Uniwave Pendant by Quantes Technology

30 minutes after using Uniwave Pendant by Quantes Technology
 A re-balanced biofield & stability.
A re-balanced biofield & stability. Significant protection from EMF, including 5G and Geopathic Stress.
Significant protection from EMF, including 5G and Geopathic Stress. Improved Physical performance.
Improved Physical performance. Energy flow and qualitative balance is restored.
Energy flow and qualitative balance is restored. Having a quality sleep.
Having a quality sleep. Enhance positivity and creativity.
Enhance positivity and creativity. Rejuvenation of cells.
Rejuvenation of cells. Increase Energy Levels.
Increase Energy Levels. Improve focus and concentration.
Improve focus and concentration. Neutralize harmful manmade and natural frequencies transmitted into beneficial energies.
Neutralize harmful manmade and natural frequencies transmitted into beneficial energies. Boost endurance, strength and vitality.
Boost endurance, strength and vitality. Enhance the body's flexibility.
Enhance the body's flexibility. Strengthen the body's immune system .
Strengthen the body's immune system . Trigger the production of stem cells for new cell formation.
Trigger the production of stem cells for new cell formation. Provide optimum energy for the healthy lifestyle.
Provide optimum energy for the healthy lifestyle.